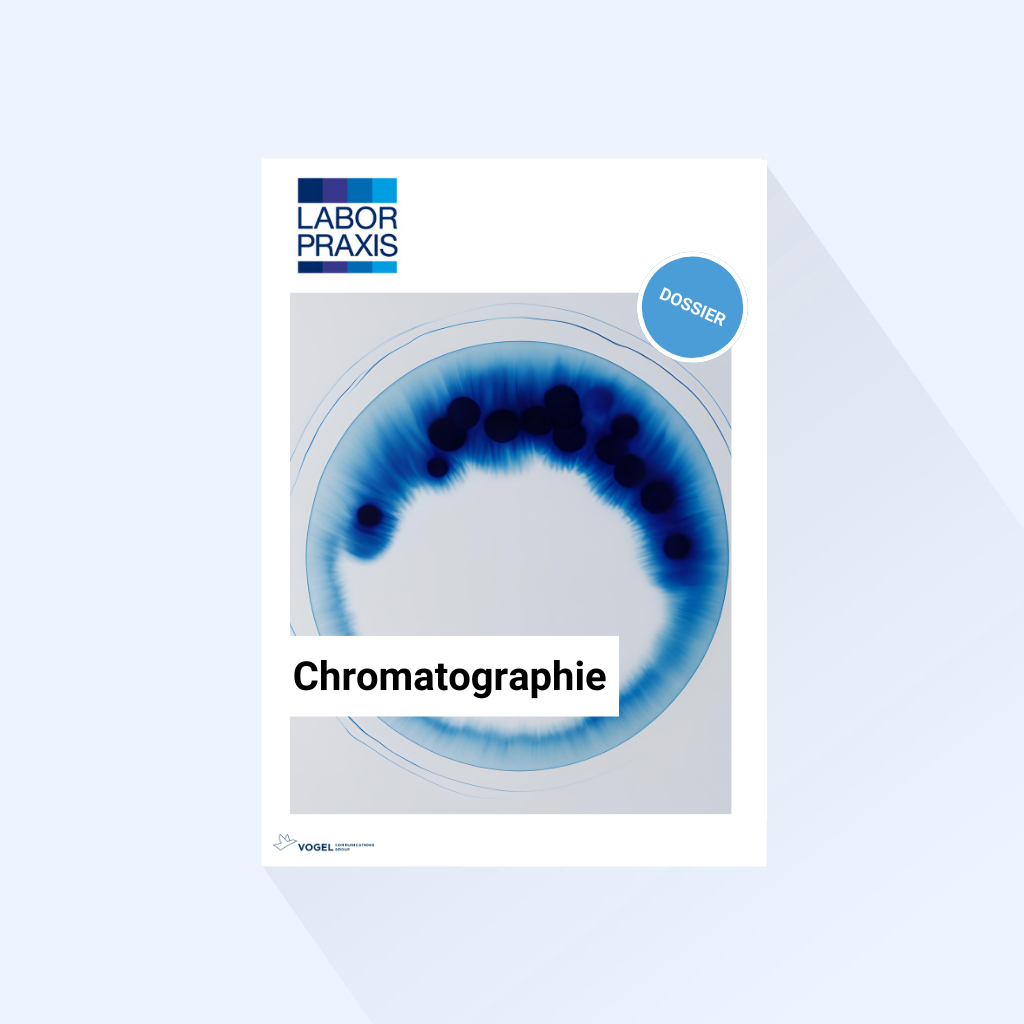

Dossier „Chromatographie“
Die Chromatographie ist eine der wichtigsten analytische Methode im Labor, egal ob es die Flüssig-, Gaschromatographie oder eine der vielen Spezialverfahren ist. Dies liegt an ihren Fähigkeiten zur Trennung, Identifizierung und Quantifizierung einzelner Komponenten auch in sehr komplexen Proben.
Was ist ein Dossier?
Bereits erschienene redaktionelle Artikel zu einem Trend-Thema werden innerhalb eines Dossiers zusammengefasst, anschließend wird das Dossier als Whitepaper hinter einer Registrierung veröffentlicht.
Sie haben aktuell keinen eigenen Content suchen aber genau zu diesem Trend-Thema Interessenten? Dann werden Sie Sponsor eines Dossiers, somit können Sie sich zu einem hochwertigen Inhalt platzieren und qualifizierte Leads generieren.
Wie läuft eine Lead Sponsoring Kampagne mit einem Dossier ab?
Wir erstellen das redaktionelle Dossier, sowie alle dazugehörigen Werbemittel für Sie. Während der Kampagnen-Laufzeit von drei Monaten werden begleitende Werbemaßnahmen umgesetzt, um die Aufmerksamkeit der Zielgruppe auf Ihr Thema zu ziehen. Hierbei wählen unsere Kampagnen-Expert:innen geeignete Maßnahmen aus, um den Kampagnen Erfolg sicher zu stellen. Der Download eines Dossiers ist erst nach einer Registrierung möglich.
Welche Leadmerkmale werden an Sie übermittelt?
Bei einem Lead Sponsoring erhalten Sie einen „Visitenkarten-Kontakt“ bestehend aus: Name, Kontaktdaten, Jobtitel, Abteilung, Karrierestufe, Branche, Firma mit Adresse, Betriebsgröße und Interesse am Thema.
Wie viele Leads werden innerhalb einer Lead Sponsoring-Kampagne mit Dossier garantiert?
Im Rahmen einer Dossier-Kampagne haben Sie die Möglichkeit ein Paket mit 75 Leads oder 120 Leads zu buchen. Jeder weitere Lead kann auf Wunsch im Anschluss der Kampagne erworben werden.
Ihr Nutzen:
- Neues Kundenpotenzial durch kontaktierbare Interessenten
- Umfangreiche Kontaktinformationen zu potenziellen Interessenten
- Keine Aufwände für die Erstellung von Whitepapern oder Werbemitteln
- Jeder Lead durchläuft eine Qualifizierung, sodass wir eine hohe Qualität der Angaben sicherstellen
- Alle Leads haben eine gültige Einwilligungserklärung
- Unsere Kampagnen-Expert:innen stellt während der Gesamtlaufzeit von 3 Monaten den Erfolg der Kampagne sicher
Natürlich gibt es bei uns auch noch andere Möglichkeiten qualifizierte Leads über unsere Fachportale zu generieren, diese erfahren Sie hier.
| Format | Lead Sponsoring Dossier 75, Lead Sponsoring Dossier 120 |
|---|---|
Hersteller |
Vogel Communications Group |
Lassen Sie uns gerne miteinander sprechen